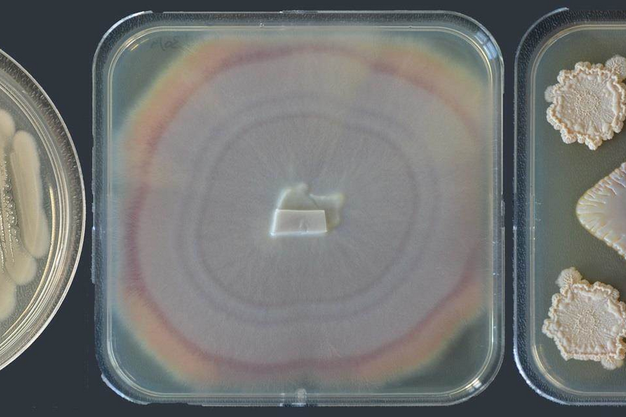

Within the Bacillus family, you can find it all, plant growth promotion, nutrient solubilization, fungicidal, and insecticidal properties. Due to their many beneficial effects, there are several uses of Bacillus spp. in agriculture. But who does what, and how does it work? The team with seed enhancement company Incotec shares more on the benefits of Bacillus against bacterial and fungal pathogens, including fusarium and phytophtora.
Biostimulant
Bacillus spp. can stimulate plant growth and development in several different ways, including through supplying different nutritional elements to the plant or through the production of growth hormones. The bacteria are able to mobilize nutrients from insoluble inorganic and organic sources. Processes like acidification, chelation, or the release of siderophores can make nutrients like phosphate, potassium, zinc and iron available to plants.
Bacillus spp. can also produce a wide range of growth hormones – auxins, IAA, cytokines, and gibberellins - that can assist the plant. Gibberellins play a role in stem growth, fruit development, cell elongation but also in response to cold temperatures. Auxins are involved in cell division, and in the processes by which the plants grow towards the light and orientate in response to gravity.
Biocontrol of pathogens
Bacillus spp can act as a biocontrol agent against a wide range of pathogens, both bacterial and fungal. Examples of fungi are Botrytis cinerea, Fusarium oxysporum, Phytophthora infestans. Bacterial examples are Erwinia amylovora and Pseudomonas syringea. For biocontrol, Bacillus spp relies on different mechanisms, such as establishment on plant tissues, antibiosis, and induction of systemic resistance.
Both space and nutrients are part of the competition between beneficial microorganisms and soil pathogens. When the beneficial microorganisms colonize the root surface there is no space left for pathogen settlement. If the beneficial microorganism is established at an early stage, it can also compete for the nutrients making survival for the pathogens even more difficult. When pathogens are present the root exudates are modified, increasing their attractiveness for Bacillus spp. which results in enhanced root colonization of the Bacillus.
Antibiosis is an interaction between two or more organisms that is detrimental to at least one of them. Bacillus spp. produce a wide variety of metabolites, enzymes, and volatiles with antimicrobial potential. An example of an enzymatic mode of action involves cell wall degrading enzymes, such as chitinases and cellulases.
Induced resistance is a physiological state of enhanced defensive capacity. Bacillus can elicit the response thereby helping the plant to boost its defences.
Protection against insects
First discovered in 1901, Bacillus thuringiensis is now a common and widely used bioinsecticide. It is toxic to certain insects when ingested. It works as follows; the bacterium produces proteins, commonly called crystalline toxins, which remain inactive until consumed by an insect. Once digested the protein is activated and binds to specific receptors in the insect's gut. When bound, the toxins pierce holes in the insect's gut, ultimately causing the contents to leak and the insects to starve. But toxins cause specific activities against insect species and different subspecies work against different insects. Bacillus thuringiensis kurstaki and Bacillus thuringiensis aizawai are effective against caterpillars, while Bacillus thuringiensis israelensis is used for the control of mosquitoes and flies and Bacillus thuringiensis tenebrionis to control beetles.
(The above-mentioned microbial genera all consist of a wide variety of species and strains. The precise beneficial effects of these microbes depend on the specific species and strain that is used)
For more information:
Incotec
www.incotec.com